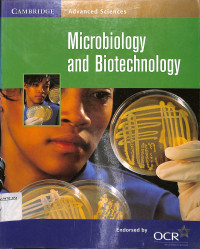
Image of Microbiology and Biotechnology

Text
Microbiology and Biotechnology
This book is part of a series of textbooks writen to provide complete coveraga of the OCR biology specification A.
Availability
#
Diponegoro 12
576 LOW
P03983S
Available
#
Diponegoro 12
576 LOW
P03984S
Available
#
Diponegoro 12
576 LOW
P03985S
Available
Detail Information
- Series Title
-
m
- Call Number
-
576 LOW
- Publisher
- Cambridge : Cambride University Press., 2008
- Collation
-
108 hal; 22 x 27,5 cm
- Language
-
English
- ISBN/ISSN
-
978-0-521-78723-9
- Classification
-
576
- Content Type
-
-
- Media Type
-
-
- Carrier Type
-
-
- Edition
-
Kedelapan
- Subject(s)
- Specific Detail Info
-
-
- Statement of Responsibility
-
Cambride University Press
Other version/related
No other version available
File Attachment
No Data
Comments
You must be logged in to post a comment
Computer Science, Information & General Works
Computer Science, Information & General Works  Philosophy & Psychology
Philosophy & Psychology  Religion
Religion  Social Sciences
Social Sciences  Language
Language  Pure Science
Pure Science  Applied Sciences
Applied Sciences  Art & Recreation
Art & Recreation  Literature
Literature  History & Geography
History & Geography